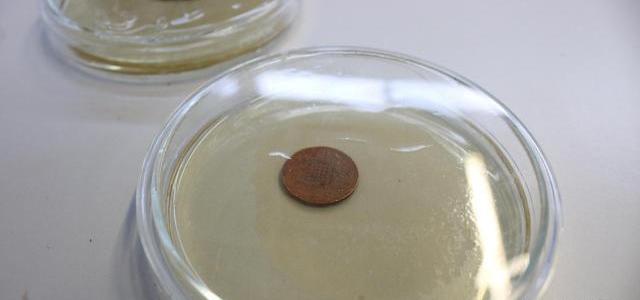

BTC/HKD-0.93%
ETH/HKD-1.13%
LTC/HKD-1.29%
ADA/HKD-1.87%
SOL/HKD-1.83%
XRP/HKD-1.13% 
本文參加百家號Billions項目組系列征文賽。
一項將在今年的歐洲臨床微生物學和傳染病大會的新研究表明,歐元紙幣比硬幣更容易受到微生物的污染。反過來說,歐元硬幣比紙幣更具抗菌的活性。來自德國漢堡大學醫學中心的約翰內斯·克諾布洛赫教授稱:即便硬幣由銅等抗菌金屬制成,但它們仍然是潛在的細菌、病污染源。

通脹數據將令歐洲央行陷入更激烈辯論:5月30日消息,歐洲央行關于貨幣政策收緊幅度的辯論可能在本周變得更趨激烈,因為政策決定公布前的靜默期即將到來,而且經濟數據料將顯示通脹率再創新高。調查的經濟學家中,除一人外,其他人都預計今年物價同比升幅將擴大,預估中值為7.8%。在歐元區四大經濟體中,只有西班牙的通脹可能不會加速上升。下一次政策會議將在6月9日舉行,歐洲央行官員將從周四開始進入靜默期。[2022/5/30 3:49:17]
在此前的很多研究中已經證實,現金有一個經常被許多個不同的人接觸的表面,被認為與病原體的傳播有關。由于歐元硬幣中銅的含量至少為75%,因此有研究認為這些零錢具有抗菌活性。
歐洲央行官員:疫情使得轉向數字貨幣的進程加速:歐洲央行官員表示,疫情使得轉向數字貨幣的進程加速。(金十)[2020/12/1 22:42:33]
在這項研究中,研究人員使用模擬皮膚接觸干污染的觸摸轉移分析法,在實際條件下研究了歐元硬幣和紙幣的抗菌活性。在實驗過程中,研究人員戴著的手套被沾染了一定量的細菌,這些細菌從一個干燥的表面傳播到硬幣或紙幣上,以模擬典型的經常接觸表面的“最壞情況”的污染。

動態 | 歐洲兩大基本港均開始應用區塊鏈:據悉,歐洲傳統的三大基本港安特衛普、鹿特丹和漢堡中,前兩者已經紛紛涉足區塊鏈技術,打造“港口+區塊鏈”。鹿特丹港口管理局近日宣布,將與區塊鏈初創企業CargoLedger合作,應用區塊鏈技術實現港口無紙化,優化港口貨物處理和追蹤以及實現港口使費的支付;安特衛普港務局和區塊鏈初創公司T-Mining共同開發了區塊鏈解決方案,使文件流轉更為安全和高效。[2018/6/26]
5歐元紙幣和所有其他歐元紙幣一樣,是由棉纖維制成的。在1歐元和2歐元的硬幣,存在“黃金”部分和“白銀”部分。“黃金”部分是合金,含75%的銅,20%的鋅和5%的鎳。“白銀”部分是白銅:75%銅和25%鎳。10分、20分和50分的硬幣是由“北歐黃金”制成的,這種合金由89%的銅、5%的鋁、5%的鋅和1%的錫組成。5分、2分和1分的硬幣是由銅包鋼制成的。
歐洲最大的民用事業公司Enel SpA將助力瑞士加密貨幣挖礦公司:歐洲最大的民用事業公司Enel SpA正洽談出售風電、太陽能和其他可再生能源類電力給瑞士數字加密貨幣挖礦公司Envion AG。[2018/1/31]
研究人員用濕的無菌棉手套觸摸表面,接觸屎腸球菌或金黃色葡萄球菌,并將它們沾在手套上。通過受污染的手套,研究人員把細菌轉移到5分、50分和1歐元的硬幣以及5歐元的紙幣上。在接觸轉移試驗中,瓷磚被用作對照表面。硬幣和紙幣的定量培養在接觸后立即進行。

在使用屎腸球菌和金黃色葡萄球菌的9個獨立實驗中,作者發現在不同貨幣表面上觀察到了不同數量的轉移細菌。控制表面和鈔票的污染顯示出相似的細菌細胞計數。
與50分和1歐元硬幣相比,5分硬幣較小的表面導致的細菌轉移量較低。所有含銅硬幣都顯示出可檢測到的抗菌活性。24小時后,5分、50分和1歐元硬幣上的金黃色葡萄球菌數量分別減少了98.7%和99.5%,屎腸球菌數量分別減少了96.8%和99.0%。相反,在鈔票上放置24小時后,細菌細胞的數量與對照組相比沒有減少。

研究人員總結道:“與5歐元紙幣相比,含銅硬幣顯示出可檢測到的抗菌活性。然而,在大多數實驗中,細菌并沒有從硬幣中完全清除。因此,即使是硬幣也可能成為微生物傳播的載體。”
最近,研究還表明,含銅表面對COVID-19具有一定的抗病活性,顯著縮短了病保持傳染性的時間,而在紙幣中由棉纖維組成的聚合表面,病可以存活數天。
但研究人員解釋,通過硬幣,甚至紙幣傳播病的風險,遠遠低于人們面對面接觸的風險。關于目前流行的COVID-19,如果必須用現金支付,硬幣會比紙幣好。
讓我們感到稍微欣慰的是,無現金支付方式,早已在中國得到普及。我們可以選擇這種不需要紙幣或硬幣,甚至不需要跟收銀員或老板發生任何接觸的方式進行支付。在抗疫期間,我們根本不用擔心紙幣或硬幣會傳播細菌或病的可能性。

FCoin舉辦某線下活動,由鏈得得編輯從視頻中截圖在這段流傳甚廣的視頻中,一群人手舉紅酒杯,圍在一個個頭不太高的年輕人身邊,觥籌交錯,相互攀談,甚是熱鬧.
1900/1/1 0:00:00原標題:兩大可樂巨頭現狀:可口可樂專注飲料行業百事謀求多元發展中國商報/中國商網(編譯年雙渡)在全球可樂市場,除了可口可樂和百事可樂外,幾乎沒有第三個品牌被消費者熟知.
1900/1/1 0:00:00比特幣誕生之后,它的去中心化特征不僅給大家帶來了新的認知,還讓嗅覺敏銳的人看到了巨大商機。隨后,出現了各種各樣模仿比特幣的區塊鏈技術,發行了各種新型加密幣,各路牛鬼蛇神紛紛跑步進場.
1900/1/1 0:00:00關注商道創投網,創投路上不迷茫↑↑↑ 韓彥是光速中國的創始合伙人,從事早期A輪融資十余年來,他的投資成績單上已經涵蓋了小鵬汽車、樊登讀書會、途家、滿幫集團等多個明星項目.
1900/1/1 0:00:00英國央行(BankofEngland)首席出納莎拉.約翰(SarahJohn)是支持央行數字貨幣的最新聲音。她表示,各國央行迅速采取行動是“至關重要的”.
1900/1/1 0:00:00南京地區作為明代的、經濟中心,墓葬出土了大量宋、明時期的金銀玉器,以首飾冠帶等飾物最為華麗.
1900/1/1 0:00:00